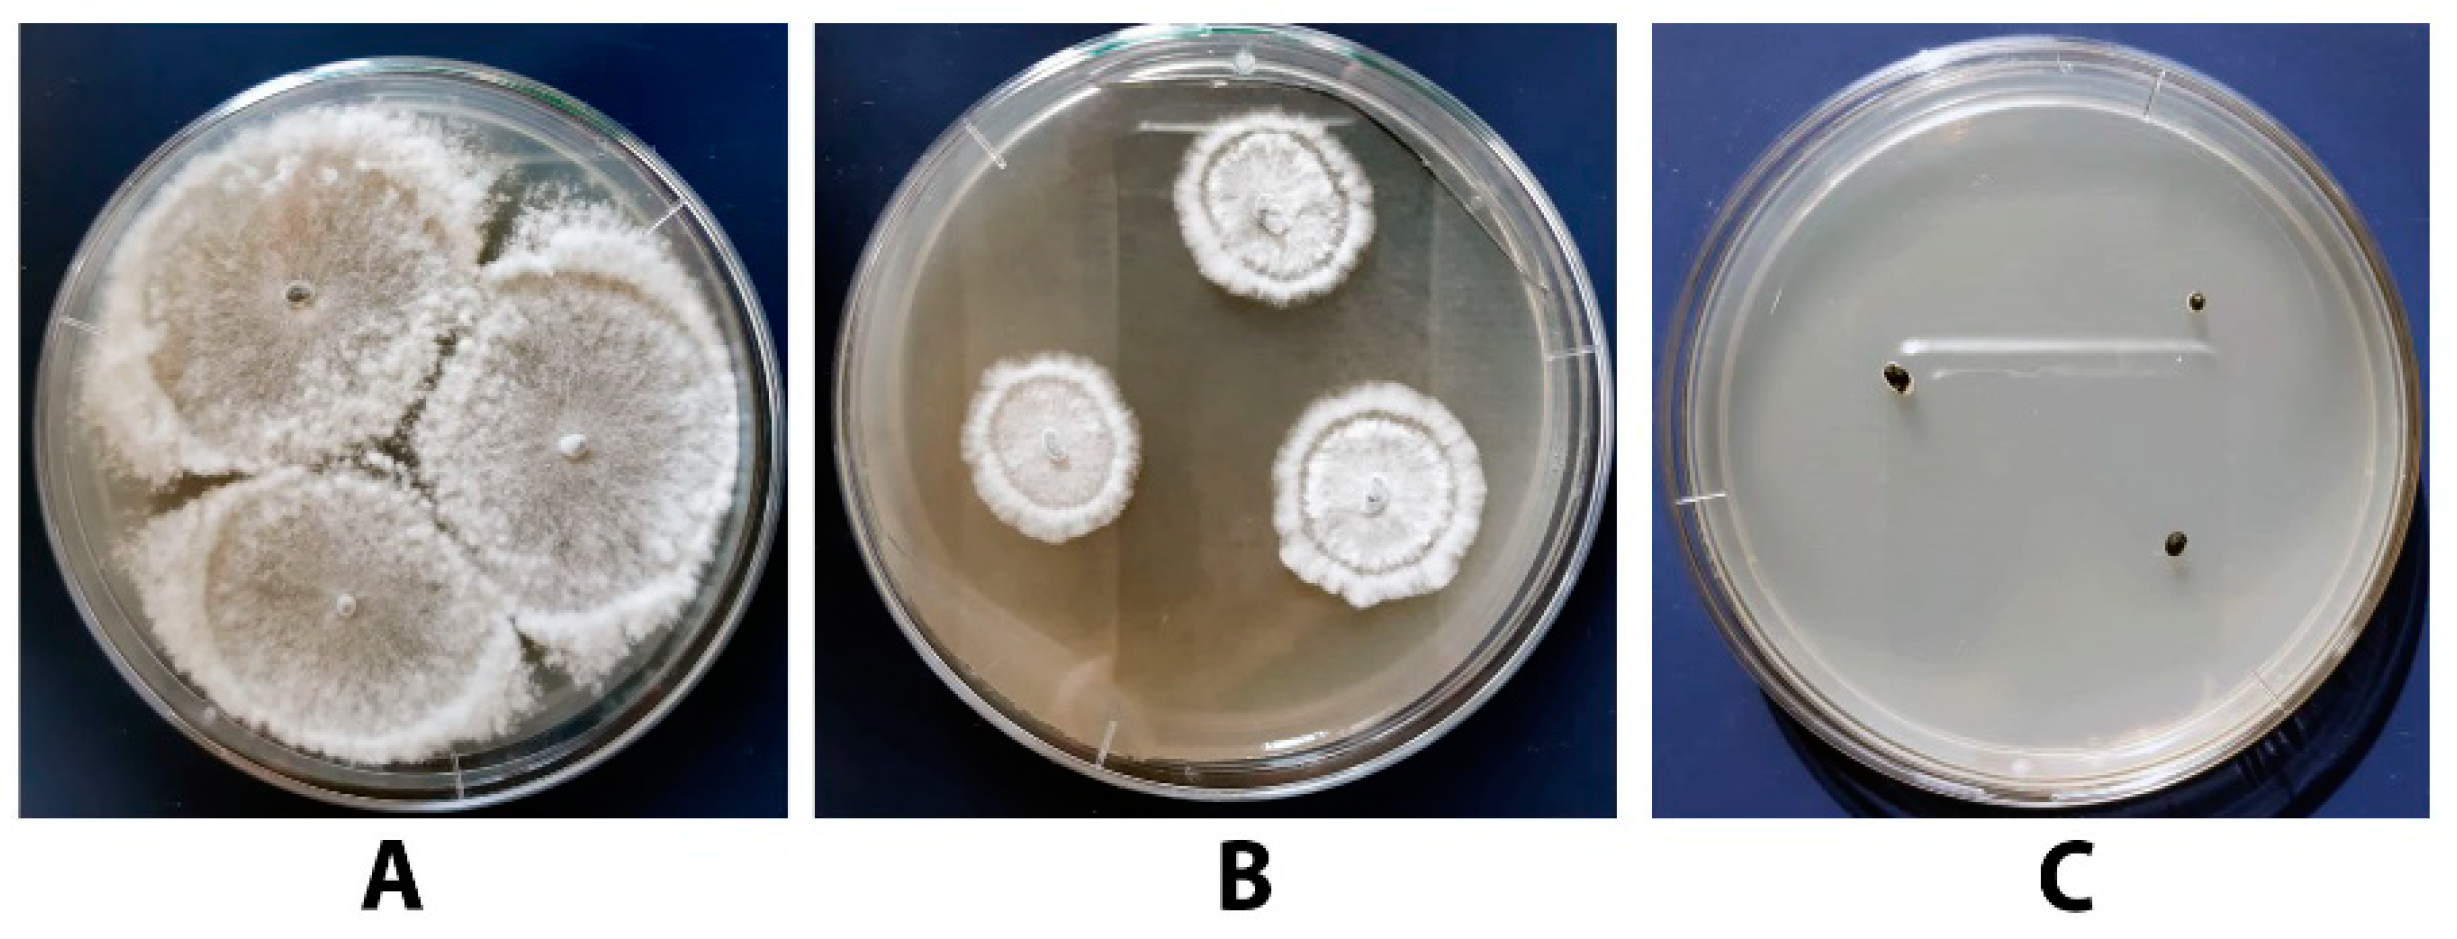
Agronomy 11 02520 g008 Agronomy 11 02520 g008
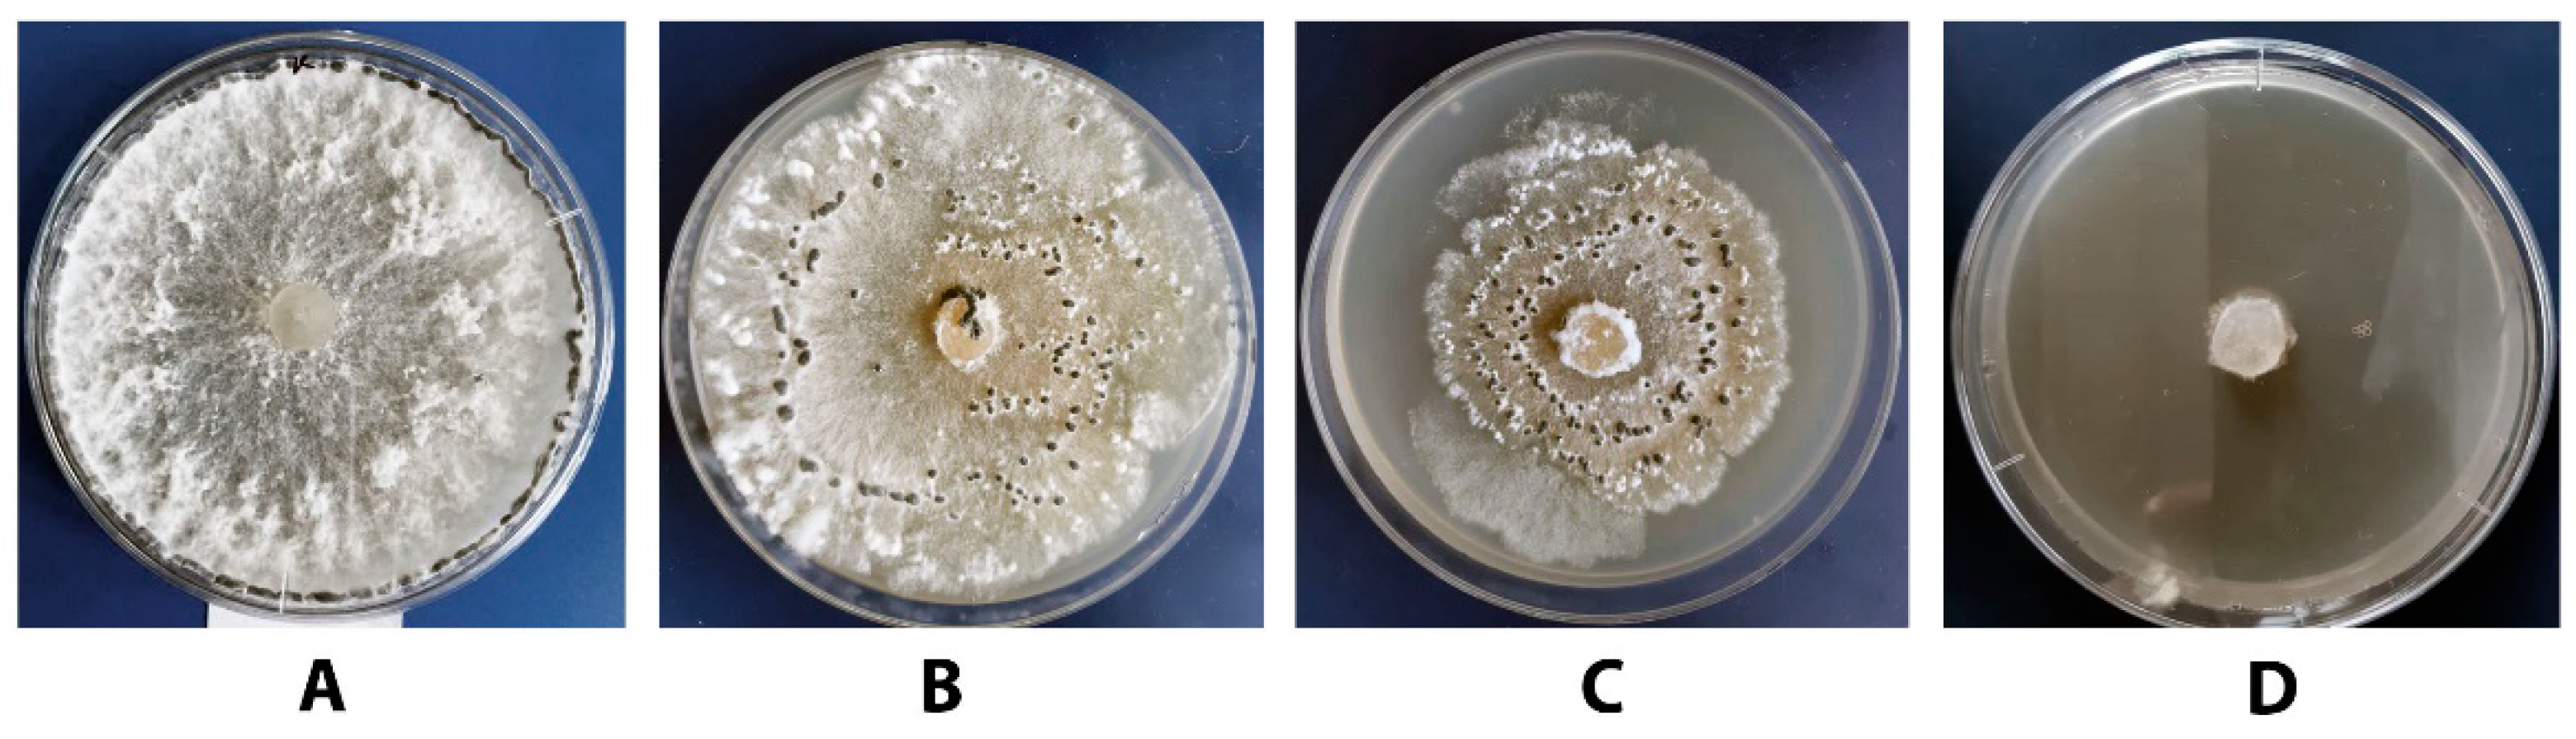
Agronomy 11 02520 g009 Agronomy 11 02520 g009
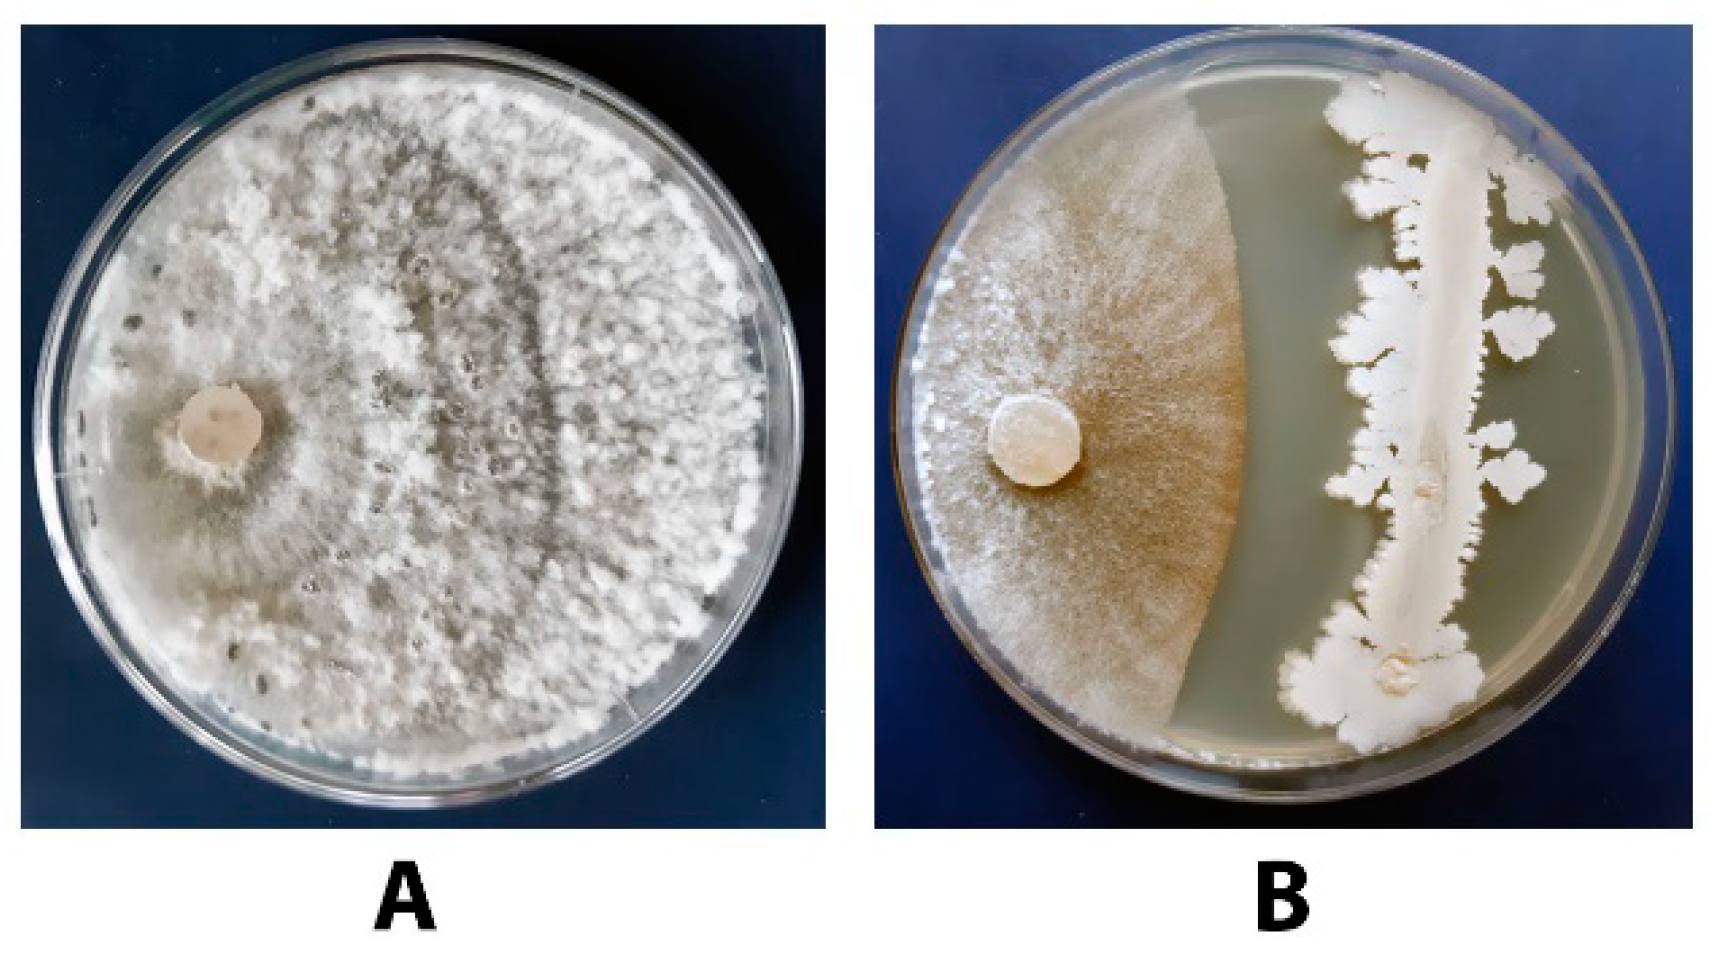
Agronomy 11 02520 g013 Agronomy 11 02520 g013

Inhibition of the Growth and Development of Sclerotinia sclerotiorum (Lib.) De Bary by Combining Azoxystrobin, Penicillium chrysogenum VKM F-4876d, and Bacillus Strains
Abstract
1. Introduction
2. Materials and Methods
2.1. Reagents
2.2. Microorganisms
2.3. Nutrient Media and Cultivation Conditions
2.3.1. Nutrient Media Compositions to Maintain Strains
2.3.2. Cultivation of P. chrysogenum VKM F-4876D in a Liquid Nutrient Medium
2.3.3. Cultivation of Bacillus Strains in a Liquid Nutrient Medium
2.3.4. Cultivation of S. sclerotiorum
2.4. Evaluation of the Antagonistic Activity by a Dual Culture Assay
2.5. Obtaining a Dry Mycelium Biomass of P. chrysogenum VKM F-4876D (DMP)
2.6. Evaluation of the DMP Antifungal Activity
2.6.1. Preparation of DMP Suspension
2.6.2. Preparation of Agar Medium Containing DMP, Azoxystrobin, or Their Combination
2.6.3. Antifungal Activity Evaluation by a Radial Growth Method
2.6.4. Effect of DMP on the Germination of S. sclerotiorum F-1-21 Sclerotia
2.7. Examination of the Antifungal Activity of DMP Combined with Bacillus Strains towards Sclerotia sclerotiorum F-1-21
2.8. Determination of Secondary Metabolites Produced by the Studied Strains
2.9. Data Treatment
3. Results
3.1. Identification of the S. sclerotiorum Strain F-1-21
3.2. Antagonistic Activity of P. chrysogenum VKM F-4876D towards S. sclerotiorum F-1-21
3.3. Effect of Different DMP Concentrations on the Growth of S. sclerotiorum F-1-21
3.4. Effect of DMP on the Germination of S. sclerotiorum F-1-21 Sclerotia
3.5. Antifungal Activity of DMP Combined with Azoxystrobin towards S. sclerotiorum F-1-21
3.6. Antagonistic Activity of the Tested Bacillus Strains towards S. sclerotiorum F-1-21
3.7. Antagonistic Activity of a Combination of DMP and B. subtilis VKM B-2998D towards S. sclerotiorum F-1-21
3.8. Determination of the Hexaene Content in Culture Broth of Bacillus Strains
3.9. Mevastatin Determination in DMP
4. Discussion
5. Conclusions
Supplementary Materials
Author Contributions
Funding
Institutional Review Board Statement
Informed Consent Statement
Data Availability Statement
Conflicts of Interest
References
- Kabbage, M.; Yarden, O.; Dickman, M.B. Pathogenic attributes of Sclerotinia sclerotiorum: Switching from a biotrophic to necrotrophic lifestyle. Plant Sci. 2015, 233, 53–60. [Google Scholar] [CrossRef] [PubMed]
- Kamal, M.M.; Savocchia, S.; Lindbeck, K.D.; Ash, G.J. Biology and biocontrol of Sclerotinia sclerotiorum (Lib.) de Bary in oilseed Brassicas. Australas. Plant Pathol. 2016, 45, 1–14. [Google Scholar] [CrossRef]
- Kamvar, Z.N.; Amaradasa, B.S.; Jhala, R.; McCoy, S.; Steadman, J.R.; Everhart, S.E. Population structure and phenotypic variation of Sclerotinia sclerotiorum from dry bean (Phaseolus vulgaris) in the United States. Peer J. 2017, 5, 41–52. [Google Scholar] [CrossRef] [PubMed]
- Oliveira, C.S.; Lião, L.M.; Alcantara, G.B. Metabolic response of soybean plants to Sclerotinia sclerotiorum infection. Phytochemistry 2019, 167, 112099. [Google Scholar] [CrossRef]
- Ding, L.-N.; Li, T.; Guo, X.-J.; Li, M.; Liu, X.-Y.; Cao, J.; Tan, X.-L. Sclerotinia Stem Rot Resistance in Rapeseed: Recent Progress and Future Prospects. J. Agric. Food Chem. 2021, 69, 2965–2978. [Google Scholar] [CrossRef] [PubMed]
- Fass, M.I.; Rivarola, M.; Ehrenbolger, G.F.; Maringolo, C.A.; Montecchia, J.F.; Quiroz, F.; García-García, F.; Blázquez, J.D.; Hopp, H.E.; Heinz, R.A.; et al. Exploring sunflower responses to Sclerotinia head rot at early stages of infection using RNA-seq analysis. Sci. Rep. 2020, 10, 13347. [Google Scholar] [CrossRef] [PubMed]
- Ojaghian, M.R.; Zhang, J.-Z.; Zhang, F.; Qiu, W.; Li, X.-L.; Xie, G.-L.; Zhu, S.-J. Early detection of white mold caused by Sclerotinia sclerotiorum in potato fields using real-time PCR. Mycol. Progress 2016, 5, 959–965. [Google Scholar] [CrossRef]
- Mao, X.-W.; Li, J.-S.; Chen, Y.-L.; Song, X.-S.; Duan, Y.-B.; Wang, J.-X.; Chen, C.-J.; Zhou, M.-G.; Hou, Y.-P. Resistance risk assessment for fluazinam in Sclerotinia sclerotiorum. Pestic. Biochem. Phys. 2018, 144, 27–35. [Google Scholar] [CrossRef]
- Elsherbiny, E.A.; Taher, M.A. Silicon induces resistance to postharvest rot of carrot caused by Sclerotinia sclerotiorum and the possible defense mechanisms. Postharv. Biol. Technol. 2018, 140, 11–17. [Google Scholar] [CrossRef]
- Guimarães, R.L.; Stotz, H.U. Oxalate production by Sclerotinia sclerotiorum deregulates guard cells during infection. Plant Physiol. 2004, 136, 3703–3711. [Google Scholar] [CrossRef]
- Riou, C.; Freyssinet, G.; Fevre, M. Production of cell wall-degrading enzymes by the phytopathogenic fungus Sclerotinia sclerotiorum. Appl. Environ. Microbiol. 1991, 57, 1478–1484. [Google Scholar] [CrossRef] [PubMed]
- Oliveira, M.B.; Barbosa, S.C.; Petrofeza, S. Comparative in vitro and in planta analyses of extracellular enzymes secreted by the pathogenic fungus Sclerotinia sclerotiorum. Genet. Mol. Res. 2013, 12, 1796–1807. [Google Scholar] [CrossRef] [PubMed]
- Bolton, M.D.; Thomma, B.P.H.J.; Nelson, B.D. Sclerotinia sclerotiorum (Lib.) de Bary: Biology and molecular traits of a cosmopolitan pathogen. Mol. Plant Pathol. 2006, 7, 1–16. [Google Scholar] [CrossRef] [PubMed]
- Monazzah, M.; Soleimani, M.J.; Enferadi, S.T.; Rabiei, Z. Effects of oxalic acid and culture filtrate of Sclerotinia sclerotiorum on metabolic changes in sunflower evaluated using FT-IR spectroscopy. J. Gen. Plant. Pathol. 2018, 84, 2–11. [Google Scholar] [CrossRef]
- Purdy, L.H. Sclerotinia sclerotiorum: History, diseases and symptomatology, host range, geographic distribution, and impact. Phytopathology 1979, 69, 875–880. [Google Scholar] [CrossRef]
- Sousa, B.; Aline, M.; Voltan, R.; Arruda, W.; Lopes, F.A.C.; Georg, R.C.; Ulhoa, C.J. Morphological and molecular aspects of sclerotial development in the phytopathogenic fungus Sclerotinia sclerotiorum. Microbiol. Res. 2019, 229, 126326. [Google Scholar] [CrossRef] [PubMed]
- Smolińska, U.; Kowalska, B. Biological control of the soil-borne fungal pathogen Sclerotinia sclerotiorum—A review. J. Plant Pathol. 2018, 100, 1–12. [Google Scholar] [CrossRef]
- O’Sullivan, C.A.; Belt, K.; Thatche, L.F. Tackling control of a cosmopolitan phytopathogen: Sclerotinia. Front. Plant Sci. 2021, 12, 707509. [Google Scholar] [CrossRef] [PubMed]
- Kolkman, J.M.; Kelly, J.D. Agronomic traits affecting resistance to white mold in common bean. Crop Sci. 2002, 42, 693–699. [Google Scholar] [CrossRef]
- Rousseau, G.; Rioux, S.; Dostaler, D. Effect of crop rotation and soil amendments on Sclerotinia stem rot on soybean in two soils. Can. J. Plant Sci. 2007, 87, 605–614. [Google Scholar] [CrossRef][Green Version]
- Huzar-Novakowiski, J.; Paul, P.A.; Dorrance, A.E. Host resistance and chemical control for management of Sclerotinia stem rot of soybean in Ohio. Phytopathology 2018, 107, 937–949. [Google Scholar] [CrossRef]
- Duan, Y.; Ge, C.; Liu, S.; Chen, C.; Zhou, M. Effect of phenyl pyrrole fungicide fludioxonil on morphological and physiological characteristics of Sclerotinia sclerotiorum. Pestic. Biochem. Phys. 2013, 106, 61–67. [Google Scholar] [CrossRef]
- Mahoney, K.J.; McCreary, C.M.; Gillard, C.L. Response of dry bean white mould [Sclerotinia sclerotiorum (Lib.) de Bary, causal organism] to fungicides. Can. J. Plant Sci. 2014, 94, 905–910. [Google Scholar] [CrossRef]
- Mc Creary, C.M.; Depuydt, D.; Vyn, R.J.; Gillard, C.L. Fungicide efficacy of dry bean white mold [Sclerotinia sclerotiorum (Lib.) de Bary, causal organism] and economic analysis at moderate to high disease pressure. Crop Protect. 2016, 82, 75–81. [Google Scholar] [CrossRef]
- Zhou, F.; Zhang, X.L.; Li, J.L.; Zhu, F.X. Dimethachlon resistance in Sclerotinia sclerotiorum in China. Plant Dis. 2014, 98, 1221–1226. [Google Scholar] [CrossRef]
- Hou, Y.-P.; Mao, X.-W.; Qu, X.-P.; Wang, J.-X.; Chen, C.-J.; Zhou, M.-G. Molecular and biological characterization of Sclerotinia sclerotiorum resistant to the anilinopyrimidine fungicide cyprodinil. Pestic. Biochem. Phys. 2018, 146, 80–89. [Google Scholar] [CrossRef] [PubMed]
- Tleuova, A.B.; Wielogorska, E.; Talluri, V.S.S.L.P.; Štěpánek, F.; Elliott, C.T.; Grigoriev, D.O. Recent advances and remaining barriers to producing novel formulations of fungicides for safe and sustainable agriculture. J. Control. Release 2020, 326, 468–481. [Google Scholar] [CrossRef]
- Komárek, M.; Čadková, E.; Chrastný, V.; Bordas, F.; Bollinger, J.-C. Contamination of vineyard soils with fungicides: A review of environmental and toxicological aspects. Environ. Int. 2010, 36, 138–151. [Google Scholar] [CrossRef] [PubMed]
- Teló, G.M.; Marchesan, E.; Zanella, R.; Peixoto, S.C.; Prestes, O.D.; de Oliveira, M.L. Fungicide and insecticide residues in rice grains. Acta Sci. Agron. 2017, 39, 9–15. [Google Scholar] [CrossRef]
- Pérez-García, A.; Romero, D.; Vicente, A. Plant protection and growth stimulation by microorganisms: Biotechnological applications of Bacilli in agriculture. Curr. Opin. Biotechnol. 2011, 22, 187–193. [Google Scholar] [CrossRef] [PubMed]
- Ma, H.-G.; Liu, Q.; Zhu, G.-L.; Liu, H.-S.; Zhu, W.-M. Marine natural products sourced from marine-derived Penicillium fungi. J. Asian Nat. Products Res. 2016, 18, 92–115. [Google Scholar] [CrossRef]
- Stein, T. Bacillus subtilis antibiotics: Structures, syntheses and specific functions. Mol. Microbiol. 2005, 56, 845–857. [Google Scholar] [CrossRef] [PubMed]
- Huber, A.; Galgoczy, L.; Varadi, G.; Holzknecht, J.; Kakar, A.; Malanovic, N.; Leber, R.; Koch, J.; Keller, M.A.; Batta, G.; et al. Two small, cysteine-rich and cationic antifungal proteins from Penicillium chrysogenum: A comparative study of PAF and PAFB. BBA Biomembr. 2020, 1862, 183246. [Google Scholar] [CrossRef] [PubMed]
- Li, Y.; Qin, L.; Roberts, D.P.; Hu, X.; Xie, L.; Gu, C.; Liao, X.; Han, P.; Liao, X. Biological fertilizer containing Bacillus subtilis BY-2 for control of Sclerotinia sclerotiorum on oilseed rape. Crop Protect. 2020, 138, 105340. [Google Scholar] [CrossRef]
- Xu, T.; Wang, Y.-T.; Liang, W.-S.; Yao, F.; Li, Y.-H.; Li, D.-R.; Wang, H.; Wang, Z.-Y. Involvement of alternative oxidase in the regulation of sensitivity of Sclerotinia sclerotiorum to the fungicides azoxystrobin and procymidone. J. Microbiol. 2013, 51, 352–358. [Google Scholar] [CrossRef]
- Dzhavakhiya, V.; Shcherbakova, L.; Semina, Y.; Zhemchuzhina, N.; Campbell, B. Chemosensitization of plant pathogenic fungi to agricultural fungicides. Front. Microbiol. 2012, 3, 87. [Google Scholar] [CrossRef] [PubMed]
- Kim, K.; Lee, Y.; Ha, A.; Kim, J.-I.; Park, A.R.; Yu, N.H.; Son, H.; Choi, G.J.; Park, H.W.; Lee, C.W.; et al. Chemosensitization of Fusarium graminearum to chemical fungicides using cyclic lipopeptides produced by Bacillus amyloliquefaciens strain JCK-12. Front. Plant Sci. 2017, 8, 2010. [Google Scholar] [CrossRef] [PubMed]
- Shcherbakova, L.; Mikityuk, O.; Arslanova, L.; Stakheev, A.; Erokhin, D.; Zavriev, S.; Dzhavakhiya, V. Studying the ability of thymol to improve fungicidal effects of tebuconazole and difenoconazole against some plant pathogenic fungi in seed or foliar treatments. Front. Microbiol. 2021, 12, 331. [Google Scholar] [CrossRef]
- Wong, F.P.; Wilcox, W.F. Comparative physical modes of action of azoxystrobin, mancozeb, and metalaxyl against Plasmopara viticola (grapevine downy mildew). Plant Dis. 2001, 85, 649–656. [Google Scholar] [CrossRef]
- Zeng, W.; Kirk, W.; Hao, J. Field management of Sclerotinia stem rot of soybean using biological control agents. Biol. Control. 2012, 60, 141–147. [Google Scholar] [CrossRef]
- Imura, N.; Ae, M.; Hoshino, R.; Abe, M.; Yamamuro, T.; Oyama, K.; Oyama, Y. Membrane hyperpolarization and depolarization of rat thymocytes by azoxystrobin, a post harvest fungicide. Chem. Biol. Interact. 2019, 300, 35–39. [Google Scholar] [CrossRef]
- Karpova, N.V.; Yaderets, V.V.; Glagoleva, E.V.; Petrova, K.S.; Ovchinnikov, A.I.; Dzhavakhiya, V.V. Antifungal activity of the dry biomass of Penicillium chrysogenum F-24-28 and its application in combination with azoxystrobin for efficient crop protection. Agriculture 2021, 11, 935. [Google Scholar] [CrossRef]
- Elazab, N.T. Diversity and biological activities of endophytic fungi at Al-Qassim region. J. Mol. Biol. Res. 2019, 9, 160–171. [Google Scholar] [CrossRef]
- Karpova, N.; Shagdarova, B.; Lunkov, A.; Il’ina, A.; Varlamov, V. Antifungal action of chitosan in combination with fungicides in vitro and chitosan conjugate with gallic acid on tomatoes against Botrytis cinerea. Biotechnol. Lett. 2021, 43, 1565. [Google Scholar] [CrossRef] [PubMed]
- Richer, D.L. Synergism: A patent view. Pestic. Sci. 1987, 19, 309–315. [Google Scholar] [CrossRef]
- Kudryashova, E.B.; Vinokurova, N.G.; Ariskina, E.V. Bacillus subtilis and phenotypically similar strains producing hexaene antibiotics. Appl. Biochem. Microbiol. 2005, 41, 486–489. [Google Scholar] [CrossRef]
- Jeon, Y.-J.; Kwon, H.-W.; Nam, J.-S.; Kim, S.H. Characterization of Sclerotinia sclerotiorum isolated from paprika. Mycobiology 2006, 34, 154–157. [Google Scholar] [CrossRef] [PubMed]
- Zhong, Y.; Peng, J.-J.; Chen, Z.-Z.; Xie, H.; Luo, D.; Dai, J.-R.; Yan, F.; Wang, J.-G.; Dong, H.-Z.; Chen, S.-Y. Dry mycelium of Penicillium chrysogenum activates defense responses and restricts the spread of Tobacco Mosaic Virus in tobacco. Physiol. Mol. Plant Pathol. 2015, 92, 28–37. [Google Scholar] [CrossRef]
- Galgóczy, L.; Papp, T.; Lukács, G.; Leiter, É.; Pócsi, I.; Vágvölgyi, C. Interactions between statins and Penicillium chrysogenum antifungal protein (PAF) to inhibit the germination of sporangiospores of different sensitive Zygomycetes. FEMS Microbiol. Lett. 2007, 270, 109–115. [Google Scholar] [CrossRef]
- Martín, J.F. Key role of LaeA and velvet complex proteins on expression of β-lactam and PR-toxin genes in Penicillium chrysogenum: Cross-talk regulation of secondary metabolite pathways. J. Ind. Microbiol. Biotechnol. 2017, 44, 525–535. [Google Scholar] [CrossRef] [PubMed]
- Kozlovskii, A.G.; Zhelifonova, V.P.; Antipova, T.V. Fungi of the genus Penicillium as producers of physiologically active compounds (review). Appl. Biochem. Microbiol. 2013, 49, 1–10. [Google Scholar] [CrossRef]
- Abbas, A.; Khan, S.U.; Khan, W.U.; Saleh, T.A.; Khan, M.H.U.; Ullah, S.; Ali, A.; Ikraf, M. Antagonist effects of strains of Bacillus spp. against Rhizoctonia solani for their protection against several plant diseases: Alternatives to chemical pesticides. Comptes Rendus Biol. 2019, 342, 124–135. [Google Scholar] [CrossRef] [PubMed]
- Gessler, N.N.; Egorova, A.S.; Belozerskaya, T.A. Melanin pigments of fungi under extreme environmental conditions (review). Appl. Biochem. Microbiol. 2014, 50, 125–134. [Google Scholar] [CrossRef]
- Shcherbakova, L.A. Fungicide resistance of plant pathogenic fungi and their chemosensitization as a tool to increase anti-disease effects of triazoles and strobilurines (review). Sel’skokhozyaistvennaya Biol. 2019, 54, 875–891. [Google Scholar] [CrossRef]
- Visagie, C.M.; Frisvad, J.C.; Houbraken, J.; Visagie, A.; Samson, R.A.; Jacobs, K. A re-evaluation of Penicillium section Canescentia, including the description of five new species. Persoonia 2021, 46, 163–187. [Google Scholar] [CrossRef]
- Grijseels, S.; Nielsen, J.C.; Nielsen, J.; Larsen, T.O.; Frisvad, J.C.; Nielsen, K.F.; Frandsen, R.J.N.; Workman, M. Physiological characterization of secondary metabolite producing Penicillium cell factories. Fungal Biol. Biotechnol. 2017, 4, 8. [Google Scholar] [CrossRef]
- Lefebvre, M.; Alshawa, K.; Dupont, B. L’activité antifongique des statins. Antifungal activity of statins. J. Mycol. Médic. 2010, 20, 212–217. [Google Scholar] [CrossRef]
- Galgóczy, L.; Papp, T.; Vágvölgyi, C. In vitro interaction between suramin and fluvastatin against clinically important zygomycetes. Mycoses 2009, 52, 447–453. [Google Scholar] [CrossRef]

| Strain | Hexaene Content in Culture Broth, mg/L | Inhibiting Activity Towards S. Sclerotiorum F-1-21 |
|---|---|---|
| Bacillus subtilis VKM В-2998D | 38.1 | +++++ |
| Bacillus subtilis VKM В-3505D | 10.8 | +++ |
| Bacillus subtilis VKM В-3154D | 13.5 | + |
| Bacillus subtilis VKM В-3155D | 28.2 | +++ |
| Bacillus subtilis VKM В-3153D | 26.4 | ++ |
Publisher’s Note: MDPI stays neutral with regard to jurisdictional claims in published maps and institutional affiliations. |
© 2021 by the authors. Licensee MDPI, Basel, Switzerland. This article is an open access article distributed under the terms and conditions of the Creative Commons Attribution (CC BY) license (https://creativecommons.org/licenses/by/4.0/).
Share and Cite
Yaderets, V.V.; Karpova, N.V.; Glagoleva, E.V.; Ovchinnikov, A.I.; Petrova, K.S.; Dzhavakhiya, V.V. Inhibition of the Growth and Development of Sclerotinia sclerotiorum (Lib.) De Bary by Combining Azoxystrobin, Penicillium chrysogenum VKM F-4876d, and Bacillus Strains. Agronomy 2021, 11, 2520. https://doi.org/10.3390/agronomy11122520
Yaderets VV, Karpova NV, Glagoleva EV, Ovchinnikov AI, Petrova KS, Dzhavakhiya VV. Inhibition of the Growth and Development of Sclerotinia sclerotiorum (Lib.) De Bary by Combining Azoxystrobin, Penicillium chrysogenum VKM F-4876d, and Bacillus Strains. Agronomy. 2021; 11(12):2520. https://doi.org/10.3390/agronomy11122520
Chicago/Turabian StyleYaderets, Vera V., Nataliya V. Karpova, Elena V. Glagoleva, Alexander I. Ovchinnikov, Kseniya S. Petrova, and Vakhtang V. Dzhavakhiya. 2021. "Inhibition of the Growth and Development of Sclerotinia sclerotiorum (Lib.) De Bary by Combining Azoxystrobin, Penicillium chrysogenum VKM F-4876d, and Bacillus Strains" Agronomy 11, no. 12: 2520. https://doi.org/10.3390/agronomy11122520
APA StyleYaderets, V. V., Karpova, N. V., Glagoleva, E. V., Ovchinnikov, A. I., Petrova, K. S., & Dzhavakhiya, V. V. (2021). Inhibition of the Growth and Development of Sclerotinia sclerotiorum (Lib.) De Bary by Combining Azoxystrobin, Penicillium chrysogenum VKM F-4876d, and Bacillus Strains. Agronomy, 11(12), 2520. https://doi.org/10.3390/agronomy11122520






